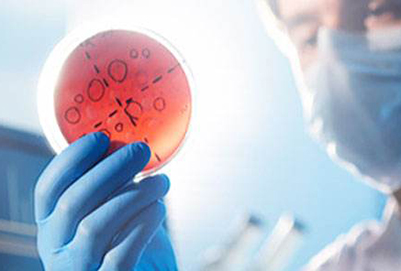
重庆医学检验专业

重庆医学检验专业学校排名最好的有哪些
作者:招生处来源:互联网时间:2025-05-07 21:44次
摘要: 重庆医学检验专业学校排名最好的有哪些? 未来就业前景怎样?我们国家这几年医学检验发展迅速,很多医院的临床检验已经在检测项目上初步实现了。为了能够有更多的有价值的检测结果
重庆医学检验专业学校排名最好的有哪些? 未来就业前景怎样?我们国家这几年医学检验发展迅速,很多医院的临床检验已经在检测项目上初步实现了。为了能够有更多的有价值的检测结果,医学检验已经成为临床医学不可缺的一部分,重庆医学检验专业学校排名最好的有哪些?今天我们一起来看看招生教育网的老师介绍。

重庆医学检验专业学校排名最好的有哪些
重庆医学检验专业学校排名最好的学校有:三峡联合职业大学信息科技学院 。随着现在检查项目的逐渐变多,并且检查的技术也在不断的提升,临床疾病诊断对医学检查的项目很是要求严格。所以检验学科的相关部门地位越来越高。不少的学生都要学习这个专业,毕竟未来的前途一片光明。

医学检专业的不断进步和检查设备的不断更新,还有对许多疾病的诊断、治疗监察和预后评估起着关键的作用。在以前的时候临床检验科室经常被做当是医院的"辅助科室",而且只对临床部门起"辅助"效果。
现阶段检验科室是各医院很关键的一个部门。是衡量一个医院整体水平的高低,还有比较关键的是这个医院的检验部门可以检测的项目有多少、检测的水平怎样,以及所应用的技术都是哪些。
重庆医学检验专业学校排名最好的有哪些?的详细介绍就是这些了,如果对此还有哪些不懂的,可以点击在线咨询,我们招生教育网老师会为大家做详细介绍。
关键词:重庆,医学检验,专业学校,排名,最,好的,有,
- 相关文章
- 重庆航空专业学校排名最好的有哪些05-07
- 重庆航空专业学校哪个比较好05-07
- 重庆高铁航空学校有哪些05-07
- 重庆医学检验专业学校哪家05-07
- 重庆空乘学校哪个好05-07
- 重庆航空专业学校排名比较好的有哪些05-07
- 重庆轨道学校学费多少05-07
- 重庆口腔专业学校一年的学费大概是多少05-07
- 重庆市沙坪坝轨道学校05-07
- 重庆轨道交通学校哪个好05-07
- 重庆口腔专业学校有哪些05-07
- 重庆读轨道交通专业怎么样05-07
推荐院校













